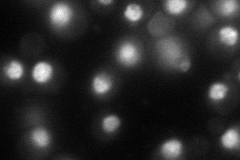
YGL092W
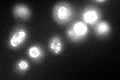
YGL092W

View description
Essential nucleoporin, catalyzes its own cleavage in vivo to generate a C-terminal fragment that assembles into the Nup84p subcomplex of the nuclear pore complex, and an N-terminal fragment of unknown function that is homologous to Nup100p
Localization:
Intensity:
Fold change:
Significance:
-
C’ GFP library in SD

nuclear periphery53.35 -
N' NOP1pr-GFP in SD
punctate,nucleus91.7903 -
N' TEF2pr-mCherry in SD

missing0 -
N' NATIVEpr-GFP in SD

punctate29.0916 -
N' TEF2pr-VC and Cyto-VN in SD

#N/A0 -
C’ GFP library in SD+DTT
nuclear periphery48.180.9No -
C’ GFP library in SD+H2O2

nuclear periphery49.160.92No -
C’ GFP library in Starvation Media

nuclear periphery46.070.86No -
C’ GFP library on the background of Pup2-DaMP

N/A -
C’ GFP library on the background of CCT mutant

N/A0N/AYes
